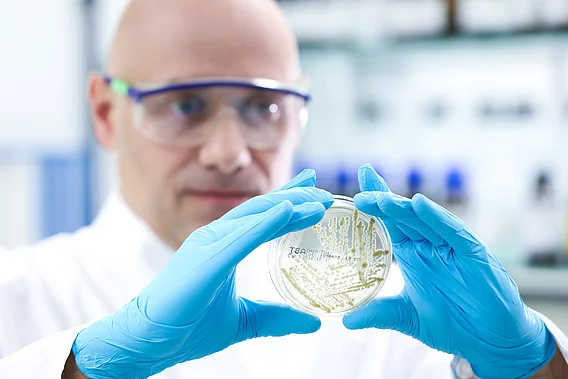

Hierbei liegt der Fokus auf:
- Magnesium in der Prävention und Behandlung verschiedener Indikationen wie unter anderem Diabetes, Herz-Kreislauf-Erkrankungen oder Migräne
- Regulation des Säure-Basen-Haushaltes als Grundvoraussetzung für die Funktionsfähigkeit zahlreicher Stoffwechselvorgänge
- Einfluss einer Basentherapie bei verschiedenen Indikationen wie unter anderem Niereninsuffizienz, chronischen Gelenkbeschwerden oder Osteoporose
Im Rahmen unserer Tätigkeiten in den obengenannten Bereichen bieten wir auch die Möglichkeit, Bachelor-, Master- und Doktorarbeiten zu begleiten. Interessiert? Jetzt bei unserer medizinwissenschaftlichen Abteilung anfragen – und mehr über die Aus- und Weiterbildungsmöglichkeiten bei Protina erfahren!
Offene Fragen?
Kontaktieren Sie uns
Haben Sie Fragen oder möchten Sie mehr über Protina erfahren? Wir freuen uns auf Ihre Nachricht:
